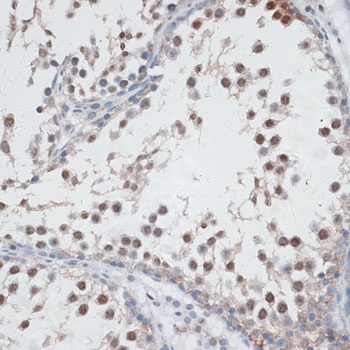
AHSP Antibody
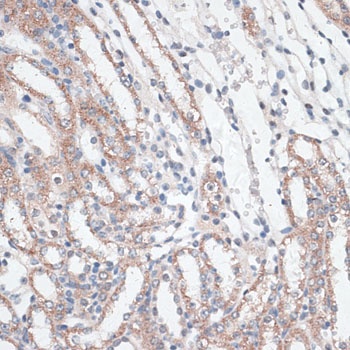
AHSP Antibody

You have no items in your shopping cart.
AHSP Antibody
Description
Images & Validation
−| Tested Applications | ELISA, IHC, WB |
|---|---|
| Dilution Range | ELISA: 1:2,000 - 1:10,000, IHC: 1:8000, WB: 1:500-1:1000 |
| Reactivity | Human, Mouse |
| Application Notes |
Key Properties
−| Antibody Type | Primary Antibody |
|---|---|
| Host | Rabbit |
| Clonality | Polyclonal |
| Isotype | Antiserum |
| Immunogen | Anti-AHSP Antibody was produced from whole rabbit serum prepared by repeated immunizations with the full length human AHSP protein. |
| Target | AHSP |
| Purity | Anti-AHSP Antibody is directed against the human AHSP protein. The product was prepared from monospecific antiserum by delipidation and defibrination. A BLAST analysis was used to suggest cross reactivity with human and mouse. Cross-reactivity with AHSP from other sources have not been determined. |
| Conjugation | Unconjugated |
Storage & Handling
−| Storage | Store vial at 4° C prior to restoration. For extended storage aliquot contents and freeze at -20° C or below. Avoid cycles of freezing and thawing. Centrifuge product if not completely clear after standing at room temperature. This product is stable for several weeks at 4° C as an undiluted liquid. Dilute only prior to immediate use. |
|---|---|
| Form/Appearance | Lyophilized |
| Buffer/Preservatives | 0.01% (w/v) Sodium Azide |
| Concentration | 115 mg/mL |
| Expiration Date | 12 months from date of receipt. |
| Disclaimer | For research use only |
Alternative Names
−Similar Products
−Rat Alpha-Hemoglobin Stabilizing Protein (aHSP) ELISA Kit [orb781538]
Rat
1.57-100 ng/mL
0.56 ng/mL
96 T, 48 TAHSP Rabbit Polyclonal Antibody [orb77530]
ELISA, IHC, WB
Mouse, Rat
Human
Rabbit
Polyclonal
Unconjugated
100 μg

Quality Guarantee
Explore bioreagents carefree to elevate your research. All our products are rigorously tested for performance. If a product does not perform as described on its datasheet, our scientific support team will provide expert troubleshooting, a prompt replacement, or a refund. For full details, please see our Terms & Conditions and Buying Guide. Contact us at support@biorbyt.com.

Immunohistochemistry of Rabbit anti-AHSP antibody. AHSP (A) stains residual EPs and not lymphoma cells in DLBCL, whereas CD71 (B) stains both lymphoma cells and EPs. C. Corresponding H&E. AHSP (D) does not metastatic carcinoma, whereas CD71 (E) does. F. Corresponding H&E. Fixation: acetic acid-zinc-formalin and formalin fixation, embedded in paraffin. Antigen retrieval: TRIS-EDTA pH9.0. Primary antibody: AHSP antibody at 1:8000 for overnight at 4°C Secondary antibody: anti-rabbit secondary at 1:10000 for 45 min at RT. Localization: Anti-AHSP is cytoplasmic. Staining: AHSP antibody as precipitated brown signal with a purple nuclear counterstain using Bond-max™ – fully automated for IHC.

Immunohistochemistry of Rabbit anti-AHSP antibody. AHSP and CD71 stain megakaryocytes in primary myelofibrosis. Tissue: A.) Primary myelofibrosis, H&E. B.) CD235a stains both nucleated EPs and mature, anucleate RBCs. AHSP C.) and CD71. D.) variably stain megakaryocytes and also stain nucleated EPs. Fixation: acetic acid-zinc-formalin and formalin fixation, embedded in paraffin. Antigen retrieval: TRIS-EDTA pH9.0. Primary antibody: AHSP antibody at 1:8000 for overnight at 4°C Secondary antibody: anti-rabbit secondary at 1:10000 for 45 min at RT. Localization: Anti-AHSP is cytoplasmic. Staining: AHSP antibody as precipitated brown signal with a purple nuclear counterstain using Bond-max™ – fully automated for IHC.

Immunohistochemistry of Rabbit anti-AHSP antibody. CD71 stains myeloid blasts in acute myeloid leukemia, whereas AHSP does not. AHSP stains residual EPs and not myeloid blasts in acute myeloid leukemia with minimal differentiation. (A), whereas CD71 stains both myeloid blasts and EPs (B). AHSP does not stain myeloid blasts in acute myelomonocytic leukemia (D), whereas CD71 does (E). C and F are corresponding H&Es, respectively. Fixation: acetic acid-zinc-formalin and formalin fixation, embedded in paraffin. Antigen retrieval: TRIS-EDTA pH9.0. Primary antibody: AHSP antibody at 1:8000 for overnight at 4°C Secondary antibody: anti-rabbit secondary at 1:10000 for 45 min at RT. Localization: Anti-AHSP is cytoplasmic. Staining: AHSP antibody as precipitated brown signal with a purple nuclear counterstain using Bond-max™ – fully automated for IHC.

Immunohistochemistry of Rabbit anti-AHSP antibody. Tissue: A.) Acute erythroleukemia, H&E. B.) CD235a stains erythroid blasts and mature, anucleate RBCs. C.) AHSP stains erythroid blasts. D.) CD71 stains erythroid blasts. Fixation: acetic acid-zinc-formalin and formalin fixation, embedded in paraffin. Antigen retrieval: TRIS-EDTA pH9.0. Primary antibody: AHSP antibody at 1:8000 for overnight at 4°C. Secondary antibody: anti-rabbit secondary at 1:10000 for 45 min at RT. Localization: Anti-AHSP is cytoplasmic. Staining: AHSP antibody as precipitated brown signal with a purple nuclear counterstain using Bond-max™ – fully automated for IHC.

Immunohistochemistry of Rabbit anti-AHSP antibody. Tissue: A.) Giant pronormoblasts are evident in parvoviral infection, H&E. B.) CD235a does not stain giant pronormoblasts. C.) AHSP and D.) CD71 stain giant pronormoblasts. Fixation: acetic acid-zinc-formalin and formalin fixation, embedded in paraffin. Antigen retrieval: TRIS-EDTA pH9.0. Primary antibody: AHSP antibody at 1:8000 for overnight at 4°C Secondary antibody: anti-rabbit secondary at 1:10000 for 45 min at RT. Localization: Anti-AHSP is cytoplasmic. Staining: AHSP antibody as precipitated brown signal with a purple nuclear counterstain using Bond-max™ – fully automated for IHC.

Immunohistochemistry of Rabbit anti-AHSP antibody. Tissue: A.) Normal bone marrow, H&E. B.) CD235a stains both nucleated EPs and mature, anucleate RBCs. C.) AHSP stains nucleated EPs, but not mature, anucleate RBCs. D.) CD71 stains nucleated EPs, but not mature, anucleate RBCs. Fixation: acetic acid-zinc-formalin and formalin fixation, embedded in paraffin. Antigen retrieval: TRIS-EDTA pH9.0. Primary antibody: AHSP antibody at 1:8000 for overnight at 4°C. Secondary antibody: anti-rabbit secondary at 1:10000 for 45 min at RT. Localization: Anti-AHSP is cytoplasmic. Staining: AHSP antibody as precipitated brown signal with a purple nuclear counterstain using Bond-max™ – fully automated for IHC.

Western Blot of Rabbit anti-AHSP antibody. Lane 1: Recombinant hAHSP (10 ng). Lane 2: Recombinant mAHSP (10 ng). Lane 3: mice Spleen cells transfected with TNS9.2-hAHSP. Lane 4: mice Spleen cells transfected with TNS9.2 control vector. Lane 5: mice Spleen cells transfected with TNS9.2-hAHSP fractionated by MACS using Ter119+ microbeads. Lane 6: mice Spleen cells transfected with TNS9.2 control vector fractionated by Ter119+. Lane 7: mice Spleen cells transfected with TNS9.2-hAHSP fractionated by Ter119-. Lane 8: Spleen cells from mice transduced with TNS9.2 control vector fractionated by Ter119-. Load: 10 ng per lane. Primary antibody: AHSP antibody at 1:1000 for overnight at 4°C. Secondary antibody: HRP Streptavidin secondary antibody at 1:40000 for 30 min at RT. Block: 5% dry milk 30 min at RT. Predicted/Observed size: ~12kDa. Other band(s): none.

Western Blot of Rabbit anti-AHSP antibody. Lane 1: Recombinant hAHSP (2 ng). Lane 2: Recombinant mAHSP (2 ng). Lane 3: RBC Lysates Mouse #24 - GFP. Lane 4: RBC Lysates Mouse #25 - GFP. Lane 5: RBC Lysates Mouse #16 - hAHSP. Lane 6: RBC Lysates Mouse #17 - hAHSP. Lane 7: RBC Lysates Mouse #22 - hAHSP. Lane 8: RBC Lysates Mouse #19 - hAHSP. Lane 9: RBC Lysates Mouse #20 - hAHSP. Load: if not described differently, 10 ng per lane. Primary antibody: hAHSP antibody, Beta-Actin antibody at 1:1000 for overnight at 4°C. Secondary antibody: HRP Streptavidin secondary antibody at 1:40000 for 30 min at RT. Block: 5% dry milk 30 min at RT. Predicted/Observed size: ~12kDa. Other band(s): none.
Quick Database Links
UniProt Details
−NCBI Reference Sequences
−| Protein | NP_057717.1 |
|---|
Documents Download
Request a Document
Protocol Information
AHSP Antibody (orb750520)
Participating in our Biorbyt product reviews program enables you to support fellow scientists by sharing your firsthand experience with our products.
Login to Submit a Review